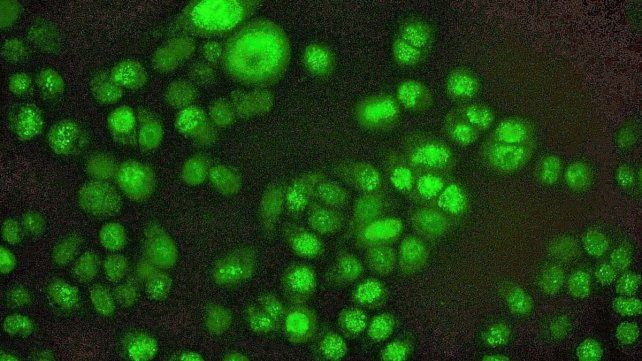
Células. De cáncer de mama triple negativo expresando la proteína Foxp3 después del tratamiento con quimioterapia. Células. De cáncer de mama triple negativo expresando la proteína Foxp3 después del tratamiento con quimioterapia.

En colaboración con colegas de España, especialistas del Conicet desarrollaron una terapia génica experimental que podría constituir -si futuros estudios lo confirman- una estrategia terapéutica para mejorar la respuesta del cáncer de mama al tratamiento estándar (quimioterapia e inmunoterapia).
Cáncer de mama: estrategia para mejorar la terapia estándar
Conicet
Células. De cáncer de mama triple negativo expresando la proteína Foxp3 después del tratamiento con quimioterapia.
Conicet
Equipo. Marianela Candolfi (derecha) y Favia Zanetti (izquierda), investigadoras del Conicet, y Alejandro Nicola Candia (centro), becario posdoctoral del Conicet.
El avance, que se describe en la revista Viruses, recibió el “Premio Bienal Florencio Fiorini en Cáncer 2023”. El tema de esta distinción -otorgada por la Liga Argentina de Lucha contra el Cáncer y la Fundación Florencio Fiorini- para el presente año es “Investigación Básica en Cáncer Humano y Experimental”.
El laboratorio de Marianela Candolfi, investigadora del Conicet en el Instituto de Investigaciones Biomédicas (INBIOMED, CONICET-UBA), y colegas demostraron en estudios in vitro y preclínicos que una proteína llamada Foxp3 es intrínseca a las células del cáncer de mama y que juega un papel importante en la patogenia de esta enfermedad mediante su capacidad para inhibir la inmunidad antitumoral y generar mayor resistencia a la quimioterapia.
“A la luz de estos resultados decidimos desarrollar una terapia génica experimental con capacidad para inhibir a la proteína Foxp3 en el interior de las células malignas y volver al tumor más sensible al efecto terapéutico de la quimioterapia y de la inmunoterapia. Lo que pudimos constatar, en estudios preclínicos, es que nuestra estrategia retrasó el crecimiento del tumor e inhibió la formación de metástasis”, explica Candolfi.
¿Cómo lo hicieron?
La terapia génica, desarrollada por el equipo de investigación del Conicet y colegas de España, consiste en el diseño de un “vehículo” constituido por adenovirus modificados genéticamente que no infectan y pueden expresar al interior de las células tumorales de mama una molécula, llamada p60, con capacidad para inhibir a la proteína Foxp3.
En estudios in vitro (con células de cáncer de mama humanas y de ratón) y preclínicos (modelos de ratón portadores de tumores de mama), el equipo de investigación observó que la terapia génica inhibía de manera efectiva a la proteína Foxp3. “Pudimos observar, sobre todo en los estudios preclínicos, que la inhibición de Foxp3 mejoró el desempeño de la inmunoterapia, es decir, de vacunas que despiertan la respuesta inmune contra el tumor”, explica Alejandro Nicola Candia, becario posdoctoral del Conicet en el grupo de Candolfi en el INBIOMED y primer autor del trabajo. Y continúa: “La supresión de Foxp3 también mejoró el desempeño de drogas quimioterapéuticas contra el tumor”.
La terapia génica, aplicada en estudios in vitro e in vivo (en ratones), se realizó en colaboración con los grupos de Flavia Zanetti, investigadora de Conicet en el Instituto de Ciencia y Tecnología Dr. Cesar Milstein (ICT Milstein), y de Juan José Lasarte, de la Universidad de Navarra, España.
Terapias combinadas
Considerando que el cáncer de mama engloba a tumores de características moleculares muy diferentes, cada subtipo de tumor tiene tratamientos específicos. En los estadios muy iniciales de la enfermedad, las pacientes acceden a la remoción quirúrgica del tumor y reciben radioterapia.
Las pacientes con tumores que expresan receptores hormonales o la molécula HER2 acceden adicionalmente a terapias hormonales específicas y anticuerpos monoclonales contra HER2. “Lamentablemente, los tumores triple negativos, que no expresan receptores de estrógeno y progesterona, ni HER2, no tienen tratamientos específicos y reciben quimioterapia, con distintos grados de éxito”, explica Candolfi.
Por otra parte, algunas pacientes reciben anticuerpos que inhiben los puntos de control inmunológico para combatir la inmunosupresión generada por el tumor. “Sin embargo, los tratamientos actuales tienen baja eficacia terapéutica en tumores metastásicos. Por lo tanto, es fundamental contar con tratamientos que mejoren la respuesta de los tumores que carecen de alternativas terapéuticas, como los triple negativos, los diseminados y los que desarrollan resistencia a la terapia”, señala Candolfi. Y agrega: “Ahora estamos profundizando los estudios preclínicos para recabar más información y evaluar la seguridad y eficacia de los tratamientos combinados, es decir, administrar la terapia génica de manera combinada con quimioterapia e inmunoterapia para reducir la quimioresistencia y la inmunosupresión en el tumor. Si sale todo bien en esta etapa, que demandaría unos cuatro años, el siguiente paso sería la realización de ensayos clínicos”.
Esta línea de investigación centrada en cáncer de mama recibe el apoyo de la Agencia Nacional de Promoción de la Investigación, el Desarrollo Tecnológico y la Innovación (Agencia I+D+I), y ahora contará con 3 millones de pesos adicionales que forman parte del “Premio Bienal Florencio Fiorini en Cáncer 2023″. “Gracias a este premio, contaremos con fondos que nos permitirán impulsar nuestro proyecto de investigación. Estoy muy agradecida y mi equipo de trabajo y colegas también lo están”, afirma Candolfi.